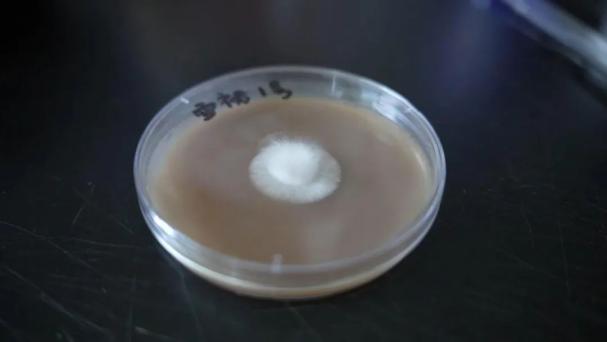

“菌中皇后”在上海奉贤安“家”,价格还会越来越亲民!
 红托竹荪,含有丰富的氨基酸、维生素以及多种矿物元素,抗癌活性远优于冬虫夏草和香菇,是世界上最珍贵的食用菌之一。过去只在野外竹林有少量生长。如今,这一主产于贵州的“菌中皇后”,在上海奉贤也安了“家”。
红托竹荪,含有丰富的氨基酸、维生素以及多种矿物元素,抗癌活性远优于冬虫夏草和香菇,是世界上最珍贵的食用菌之一。过去只在野外竹林有少量生长。如今,这一主产于贵州的“菌中皇后”,在上海奉贤也安了“家”。就在奉贤区金海街道,位于此地的上海市农业科学院食用菌研究所(以下简称上海市农科院食用菌所),通过5年时间,对该菌株的不断驯化选育和技术攻关,目前已成功实现红托竹荪的规模化栽培、周年化种植、试点化推广。
今天“开吃吧!奉贤”第二站,就来到了金海街道,走进了红托竹荪的新家,一起去看看它是怎么诞生的吧!
1
瞄准新赛道
回应人民群众日益多元化的食物消费需求
 深绿色的菌帽,呈红色的菌托,雪白的裙摆,眼前这株造型独特的食用菌,就是“红托竹荪”。现在,作为奉贤的“常住居民”,它有了一个新名字“雪裙1号”。每隔一段时间,它们就会在上海市农业科学院(以下简称市农科院)食用菌研究所里“出生”“长大”,然后去全国各地“开花”“结果”。
深绿色的菌帽,呈红色的菌托,雪白的裙摆,眼前这株造型独特的食用菌,就是“红托竹荪”。现在,作为奉贤的“常住居民”,它有了一个新名字“雪裙1号”。每隔一段时间,它们就会在上海市农业科学院(以下简称市农科院)食用菌研究所里“出生”“长大”,然后去全国各地“开花”“结果”。中国,是世界上唯一在传统上食用竹荪的国家。竹荪入馔,最早记录见之于山东曲阜孔府《进贡册》。但竹荪对生产环境极为苛刻,在野外,如果没有潮湿阴凉的竹林,没有相对适宜的温度,是很难长大的。因此,数百年来,竹荪一直因其产量稀少,被封为膳食珍品。其中,红托竹荪因气息清香在“种群”里更显珍贵,被誉为“雪裙仙子”“真菌之花”“菌中皇后”。
2017年,中央一号文件将食用菌产业列为“优势特色产业”之一。上海虽然没有复杂的地形地貌和多样的森林环境,很难孕育出野生菌,但在食用菌新品种、新技术的研发引领和辐射带动方面一直走在前列,中央一号文件为其发展现代农业提供了新的探索方向。
作为上海农业大区之一,中国建所最早的食用菌专业研究所,上海市农科院食用菌所就落户在奉贤。这所成立于1960年的研究所,在食用菌纯菌种制备、杂交育种理论及技术开发、野生食用菌人工栽培技术开发,以及代料栽培理论和技术研发、工厂化生产等方面已经拥有诸多成功经验,2019年起就响应国家号召率先进入“培育和壮大食用菌产业”赛道中,对野生的红托竹荪进行驯化研究,并致力于红托竹荪的工厂化栽培技术集成与应用。
 上海市农业科学院食用菌研究所高级农艺师周峰说,红托竹荪市场需求大、经济效益好、营养价值高,但是老百姓接触它的机会却不多,“我们希望这个品种可以在上海进行熟化,然后在全国进行一个推广,更好满足人民群众日益多元化的食物消费需求。”
上海市农业科学院食用菌研究所高级农艺师周峰说,红托竹荪市场需求大、经济效益好、营养价值高,但是老百姓接触它的机会却不多,“我们希望这个品种可以在上海进行熟化,然后在全国进行一个推广,更好满足人民群众日益多元化的食物消费需求。”2
找准突破点
攻克红托竹荪栽培技术难点
 当时,国内有些地方已经把红托竹荪当作致富农产品来种植,也取得了长足进步,但主要以季节性大棚栽培为主,产业规模一直较小。首先是竹荪的种植技术并不简单,没有技术支持,菌包容易受到污染,种植就很难成功。除了种植技术门槛高,竹荪的采摘也是一大难题。主要原因是竹荪的采摘期很短,只有几个小时,如果种植成功,长成后没能及时采摘,竹荪就会“凋谢”。
当时,国内有些地方已经把红托竹荪当作致富农产品来种植,也取得了长足进步,但主要以季节性大棚栽培为主,产业规模一直较小。首先是竹荪的种植技术并不简单,没有技术支持,菌包容易受到污染,种植就很难成功。除了种植技术门槛高,竹荪的采摘也是一大难题。主要原因是竹荪的采摘期很短,只有几个小时,如果种植成功,长成后没能及时采摘,竹荪就会“凋谢”。 经过技术攻关与不断试验,科研人员们发现,推广运用液体菌种制种、工厂化立体式栽培等新技术新模式,可以实现红托竹荪的规模化、周年化种植。周峰说,整个研发过程中,科研人员首先攻克了液体菌种技术,把菌种的生长周期从原来的七八个月缩短至一个多月。使用液体菌种技术,还可以把污染率控制在5%以下。此外,在栽培技术方面,创新“智慧方舱”数字化种植模式,“通过对温度、湿度等环境参数的优化和调整,促进红托竹荪的快速生长。”目前,从菌包覆土到收成,只需要3个多月的时间,相比农法栽培来说,周期缩短了整整2个月。
经过技术攻关与不断试验,科研人员们发现,推广运用液体菌种制种、工厂化立体式栽培等新技术新模式,可以实现红托竹荪的规模化、周年化种植。周峰说,整个研发过程中,科研人员首先攻克了液体菌种技术,把菌种的生长周期从原来的七八个月缩短至一个多月。使用液体菌种技术,还可以把污染率控制在5%以下。此外,在栽培技术方面,创新“智慧方舱”数字化种植模式,“通过对温度、湿度等环境参数的优化和调整,促进红托竹荪的快速生长。”目前,从菌包覆土到收成,只需要3个多月的时间,相比农法栽培来说,周期缩短了整整2个月。上海市农科院食用菌研究所助理研究员杨焕玲说,目前,从菌包到收成,只需要3个多月的时间,相比农法栽培来说,周期缩短了整整2个月。每个智慧方舱有2000个菌包,每个菌包的产量大概在100~125克左右,大幅提升了红托竹荪的产量和品质,形成了稳定的经济模式,红托竹荪的价格也更趋于稳定,一般在40元到60元每斤。
3
技术的进步
让食用菌产业逐渐壮大
 随着红托竹荪的栽培技术从传统走向现代,这小小的食用菌也变得越来越常见。眼下,通过盒马鲜生、叮咚买菜等电商平台,市民们就能看到“奉贤产”的红托竹荪了。
随着红托竹荪的栽培技术从传统走向现代,这小小的食用菌也变得越来越常见。眼下,通过盒马鲜生、叮咚买菜等电商平台,市民们就能看到“奉贤产”的红托竹荪了。 63岁的煲汤达人张莉君就是尝鲜者之一,考虑到6月是滋补益气的好时节,她便爱上了红托竹荪这一“煲汤必备菌”。随着红托竹荪在农家厨房里幻化出不同的滋味,也意味着,菌农们的钱袋子鼓起来了,老百姓的“菜篮子”也丰富起来了。奉贤区农业技术推广中心园艺科科长李丹介绍,依托上海市农科院技术,区农业技术推广中心一直在致力于推广野生食用菌的人工栽培技术,“按照‘成熟一个推广一个’原则,将越来越多的野生食用菌推介给全国各地的合作社和生产基地,让它们的价格越来越亲民,让越来越多的人吃得好、吃得安全、吃得健康。”目前,在全国,共有800多个智慧方舱,正在试点规模化种植红托竹荪。
63岁的煲汤达人张莉君就是尝鲜者之一,考虑到6月是滋补益气的好时节,她便爱上了红托竹荪这一“煲汤必备菌”。随着红托竹荪在农家厨房里幻化出不同的滋味,也意味着,菌农们的钱袋子鼓起来了,老百姓的“菜篮子”也丰富起来了。奉贤区农业技术推广中心园艺科科长李丹介绍,依托上海市农科院技术,区农业技术推广中心一直在致力于推广野生食用菌的人工栽培技术,“按照‘成熟一个推广一个’原则,将越来越多的野生食用菌推介给全国各地的合作社和生产基地,让它们的价格越来越亲民,让越来越多的人吃得好、吃得安全、吃得健康。”目前,在全国,共有800多个智慧方舱,正在试点规模化种植红托竹荪。其实,在食用菌大军里,不只是红托竹荪在奉贤有了家。云南的“金耳”妹妹,甘肃的“羊肚菌”哥哥,还有黑龙江的“猴头菇”弟弟……都在这里有了全新的“生活体验”。根据区农业技术推广中心统计,奉贤本地已形成以草菇、大球盖菇、羊肚菌为主规模化种植试点区域,“我们2023年食用菌的年产值近2200万元,产量达到1600多吨。”李丹说。
 去年,市农业农村委、奉贤区人民政府、市农科院三方还签署了战略框架协议,共同推进上海农业科创谷的建设,试图在上海乡村振兴版图上,探索出具有独特魅力的新质生产力。其中,在产业谋划上,就依托市农科院资源,加强育种技术创新与品种选育,做强现代种业。考虑到食用菌产业已列为中国农业(粮食、蔬菜、果树、油料、食用菌)第五大产业,未来,在上海农业科创谷建设中,还将持续关注食用菌新品种的选育、引进、栽培、扩繁、开发及工厂化生产等技术,做大农业“芯片”这篇文章。相信未来,奉贤的“食用菌王国”会越来越庞大,食用菌产业也会越做越做强。
去年,市农业农村委、奉贤区人民政府、市农科院三方还签署了战略框架协议,共同推进上海农业科创谷的建设,试图在上海乡村振兴版图上,探索出具有独特魅力的新质生产力。其中,在产业谋划上,就依托市农科院资源,加强育种技术创新与品种选育,做强现代种业。考虑到食用菌产业已列为中国农业(粮食、蔬菜、果树、油料、食用菌)第五大产业,未来,在上海农业科创谷建设中,还将持续关注食用菌新品种的选育、引进、栽培、扩繁、开发及工厂化生产等技术,做大农业“芯片”这篇文章。相信未来,奉贤的“食用菌王国”会越来越庞大,食用菌产业也会越做越做强。红托竹荪身份信息
竹荪主要生长在贵州、云南、四川等地。
1976年
红托竹荪是我国真菌学家臧穆等人于1976年在云南发现并命名的新种,因菌托呈红色,当遇强光或机械损伤会变成蓝色、紫红色而得名。
1983年
1983年,贵州省织金县科技人员对野生的红托竹荪进行驯化研究,花两年时间才栽培成功,因此,贵州省织金县不仅获得“织金竹荪”的地理标志产品认证,2000年还被中国食用菌协会授予“中国竹荪之乡“的称号。
2000年
2000年,中国食用菌协会常务理事、副秘书长、《中国食用菌》杂志主编张光亚研究员与贵州科学院高级工程师王英杰到织金考察发现,红托竹荪是食用菌物种中最珍贵的一种,又是竹荪家族中品质最好的一种。
2019年
2019年起,上海市农业科学院食用菌研究所开始对红托竹荪进行“工厂化栽培技术集成与应用”研究,目前选育出品种“雪裙1号”,正在申请上海市品种认定。
原标题:《“菌中皇后”在上海奉贤安“家”,价格还会越来越亲民!》

